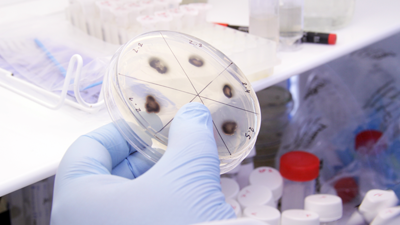
University of Edinburgh

Instruments of the Afterlife, 2015
Instruments are created to transform toxic matter into valuable materials by employing plants and engineered bacteria. Instead of mining material from geological sources and using fossil fuels that lead to environmental harm, could future generations use the contamination and pollution we leave behind to build their future world? Can they build balanced relationships with the natural world and through technology can they be better planetary citizens?
In response, a series of new instruments use synthetic biology, plant science and nanotechnology. Whilst cleaning the land, they remember the mistakes of the past.
Ultimately the instruments disrupt how we have used the land in the past and transform how we extract planetary resources in the future.
Supported by the EPSRC and CORE at Loughborough University.
Made in collaboration with five leading universities at Birmingham, Cranfield, Edinburgh, Newcastle & Warwick.

Photo by Lenka Rayn H
|
"Close a pit, kill a community" This slogan, adopted by Welsh miners during the struggles against the mine closures in the 1980s, marks the significance between land, industry and community. Welsh miners, like their counterparts across the UK, knew the importance of the land as the lifeblood of the mining community. This close-knit community prospered during the industrial revolution, but as energy preferences changed, the pits closed and its community slowly disbanded. |
|
What remains in the traces of heavy metals in the soil, is a shadow of the people and a disappearing way of life.Today we face the consequences of the fossil fuels that powered the industrial revolution - from environmental change, to an exploding global population with a hunger for materials to build the new world. Technological progress ushers in the next revolution that will build new relationships with our environment through synthetic biology, plant science and nanotechnology.
In response, an art piece presents a future where the cleaning of polluted land is shaped by an alternative set of beliefs that could mould the new technological revolution.
The Instruments, Photo by nickrphotographyA set of instruments have been created to promote a system of mutual relationships between humans, plants, bacteria and fungi. The system recovers valuable nanometals from the contaminated soil. Instead of using fossil fuels (the remains of life forms from the distant past), technology now uses the contamination left behind by the miners and more recent communities.
The instruments use new scientific research. One of these, the Bioacoustic Locator, is designed to be a communication tool between plants and humans. It is based on the findings that plants are attracted towards 220Hz vibrations, the same frequency as running water underground. The growth of young plants are also stimulated by similar vibrations. Composer Neil Luck has created a musical score for the instruments to achieve the frequences to draw the plants roots towards the contamination hotspots. At the same time it creates an act of remembrance for human ears.
Therefore the musical vibrations produced by the instruments celebrate the past communities’ contribution to the present whilst creating physical material from their lives to build the future. This functionality of the instruments moves humans towards a web of relationships between many living components, similar to those found in the biosphere. Together, we enter a future vision where our energy needs and planetary consumption are balanced - aiming to achieve self-sustaining systems with limited impact.

Bioacoustic Locator, Photo by Lenka Rayn H.


Digester, Photo by Lenka Rayn H.

Bacteria Tank, Photo by Lenka Rayn H.

Instruments which include the Bioacoustic Locator are important tools of the Transformosphere as featured in the below diagram.

Each instrument in the range is designed specifically for the particular contaminants found in the soil.
These instruments are used by a group of workers to clean the land. They visit the sites on a daily basis to tend to the plants that are absorbing the pollution and extract it as valuable materials by using engineered bacteria. Energy and material is harvested at each step of the process to ensure there is no waste within the system.
Beyond the functionality of the process, it also creates a memorial for the events that happened here and the people who lived and worked on this land before their upheaval. For the launch of the Instruments of the Afterlife at the V&A, we concentrate on the decline of the mining industry in the UK and a disappearing way of life for those communities. In future performances, the instruments may be used to transform contamination left behind from other significant events.
Events may include disasters such as the nuclear legacy of Fukushima in Japan, sites of warfare ranging from WW2 to more recent conflicts and the e-waste discarded from dumped technology. In each context new instruments, musical scores and processes will be designed for the memorial cleaning system according to the contaminates present in the soil and the corresponding synthetic biology engineered to harvest them.
The piece is based on the scientific research, 'Cleaning Land for Wealth', funded by the UK's Engineering and Physical Sciences Research Council.
This innovative research project involves a number of leading British Universities.
Cleaning Land for Wealth (CL4W) The scientific research uses bacteria to produce nanoparticles from plants, which can be used to collect contaminants. The idea is to bring back to life areas of land lost through centuries of misuse, making land decontamination financially viable, and providing our manufacturing industries with new material, without the need for mining or smelting. But just how much wealth really is beneath our feet? In short, it is very significant. Globally, substantial land contamination exists and blights the lives of millions, but it is poorly quantified, particularly within poor and developing nations where there is limited financial motivation for this to be addressed. We do know that there are nearly three million 'polluting activities' and 350,000 sites affected by soil contamination that could cost €350bn to treat in the European Union....Almost two-thirds of the contaminated land in England and Wales contains metals (....and metalloids) - with arsenic and nickel accounting for about 40% of this. We have chosen to shine a light on our research through the lens of artists BurtonNitta with help from the Creative Outreach Resource Efficiency.
|
|
Acknowledgements
Instruments of the Afterlife
by
Burton Nitta (Michael Burton & Michiko Nitta)
In collaboration with
Artistic team
Composer: Neil Luck
Musician: Lawrence Tatnall
Performer: Timothy Cape (Bastard Assignments)
Performer: Josh Spear (Bastard Assignments)
Actor: Emily Lloyd-Saini
Scientific team
Cleaning Land for Wealth (CL4W) (Link here)
University of Warwick (Link to CL4W webpage here)
Dr. Guy Barker
Dr. Louise Horsfall
Dr. Matthew Edmundson
Dr. Michael Capeness
Dr. Virginia Echavarri-Bravo
Newcastle University
Prof. Adam Harvey
Dr. Valentine Eze
University of Birmingham
Dr. David Book
Dr. Dan Reed
Cranfield University
Dr. Philip Longhurst
Dr. Ying Jiang
Loughborough University
Creative Outreach For Resource Efficiency(CORE): Prof. Jacqui Glass
Supported by

Press list
Case Study: CL4W scientists and Instruments of the Afterlife
Publication: Crafting Our Digital Futures by Irini Papadimitriou, Andrew Prescott and Jon Rogers,2015, ISBN:978-0-9576868-4-7
The Larva, the test tubes, and the Trombone by Professor Jacqui Glass, 1st October 2015
When Arts meets Science by Jo Philips, .Cent magazine, 27th August 2015
Performances
|
|

Performance @ V&A, Photo by Daniel Kupsovsky

Performance@ V&A, Photo by nickrphotography